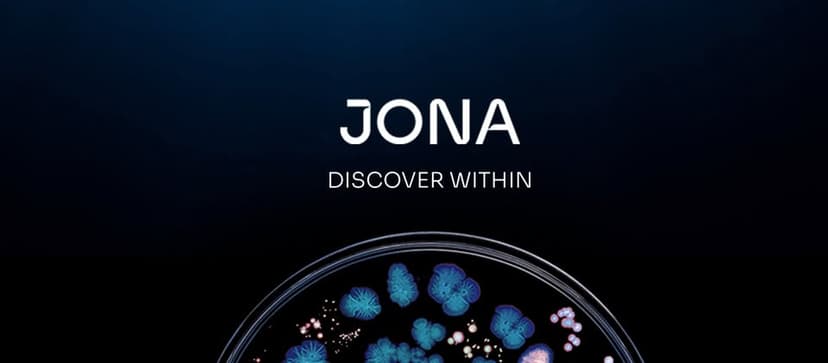

The microbiome is a fascinating world of tiny organisms living inside and on our bodies. These microbes, which include bacteria, viruses, and fungi, play a vital role in our health. They help with digestion, keep our immune system strong, and even affect our mood. Scientists are still uncovering the many ways these tiny creatures impact our lives.
Key Takeaways
- The microbiome consists of trillions of bacteria, viruses, and fungi living in and on our bodies.
- A healthy microbiome is crucial for good digestion and a strong immune system.
- Imbalances in the microbiome can lead to health problems like obesity, heart disease, and diabetes.
- Diet, medications, and lifestyle choices can all influence the health of our microbiome.
- Researchers are exploring new ways to use the microbiome to treat and prevent diseases.
What is the Microbiome?
Definition and Components
The microbiome is a collection of trillions of microorganisms, including bacteria, viruses, fungi, and other tiny life forms, that live in and on our bodies. These microorganisms are crucial for our health and well-being. They are found in various parts of the body, such as the skin, mouth, and especially the gut.
Historical Perspective
In 1675, Antonie van Leeuwenhoek, a Dutch scientist, first observed these tiny creatures through a microscope. He called them “animalcules.” Since then, our understanding of these microorganisms has grown significantly, revealing their essential role in our health.
Microbiome vs. Microbiota
While the terms microbiome and microbiota are often used interchangeably, they are not the same. The microbiota refers to the actual microorganisms living in a specific environment, like the gut. The microbiome, on the other hand, includes the microorganisms and their genetic material. This distinction helps scientists study not just the organisms but also their functions and interactions within their environment.
The Gut Microbiome and Its Importance
Role in Digestion
The gut microbiome plays a crucial role in breaking down food and absorbing nutrients. These microorganisms help digest complex carbohydrates, proteins, and fats that our bodies can't process on their own. They produce essential vitamins like B and K, and short-chain fatty acids that nourish the gut lining.
Impact on Immune System
A healthy gut microbiome is vital for a strong immune system. It helps to train the immune system to distinguish between harmful and harmless substances. This prevents overreactions that can lead to allergies and autoimmune diseases. The gut microbiome also produces antimicrobial substances that fend off harmful pathogens.
Connection to Mental Health
The gut-brain axis is a communication network linking the gut and the brain. The gut microbiome produces neurotransmitters like serotonin, which influence mood and mental health. An imbalance in gut bacteria has been linked to conditions such as depression and anxiety. Maintaining a healthy gut microbiome can therefore support mental well-being.
The gut microbiome is not just about digestion; it plays a key role in overall health, including immune function and mental health.
Microbiome and Disease Prevention
Obesity and Metabolic Disorders
The microbiome plays a crucial role in regulating metabolism and body weight. A balanced microbiome can help prevent obesity and related metabolic disorders by influencing how the body stores fat and uses energy. Researchers are exploring how altering the gut microbiome might offer new treatments for obesity.
Cardiovascular Health
A healthy microbiome contributes to heart health by reducing inflammation and improving cholesterol levels. Certain gut bacteria produce substances that help lower blood pressure and protect against heart disease. Maintaining a balanced microbiome through diet and lifestyle can be a key strategy in preventing cardiovascular issues.
Cancer Risk Reduction
Emerging studies suggest that the microbiome may help reduce the risk of certain cancers. Some gut bacteria can produce compounds that protect cells from damage and support the immune system in identifying and destroying cancer cells. Future research aims to better understand these mechanisms and how they can be harnessed for cancer prevention.
The link between the microbiome and its role in disease continues to be researched. Yet, studies have shown its impact on both physiological health and even mental health. A healthy microbiome can reduce the risk of obesity, heart disease, diabetes, and cancer.
Environmental Influences on the Microbiome
Diet and Nutrition
The food you eat plays a big role in shaping your gut microbiome. A diet rich in fiber, fruits, and vegetables promotes a diverse and healthy microbiome. On the other hand, a diet high in processed foods and sugars can harm it. Different foods provide different nutrients that help various types of bacteria grow. For example, fiber acts as food for good bacteria, helping them thrive.
Antibiotics and Medications
Antibiotics can kill both harmful and beneficial bacteria in your gut. This can lead to a less diverse microbiome, making it easier for bad bacteria to take over. Other medications, like antacids and painkillers, can also affect your gut bacteria. It's important to use antibiotics only when necessary and to follow your doctor's advice.
Lifestyle Factors
Your daily habits can also impact your microbiome. Regular exercise, good sleep, and low stress levels contribute to a healthier gut. Smoking and excessive alcohol consumption, however, can harm your gut bacteria. Simple lifestyle changes can make a big difference in maintaining a balanced microbiome.
A balanced microbiome is essential for overall health. Small changes in your diet and lifestyle can have a big impact on your gut health.
Therapeutic Potential of the Microbiome
Probiotics and Prebiotics
Probiotics are live bacteria that can provide health benefits when consumed. They help maintain a healthy balance of gut bacteria, which can prevent harmful bacteria from taking over. Prebiotics, on the other hand, are non-digestible fibers that feed these beneficial bacteria. Together, they can improve digestion and boost the immune system. Some common sources of probiotics include yogurt, kefir, and fermented foods, while prebiotics are found in foods like bananas, onions, and garlic.
Fecal Microbiota Transplantation
Fecal Microbiota Transplantation (FMT) involves transferring stool from a healthy donor to the gastrointestinal tract of a patient. This procedure aims to restore the balance of bacteria in the gut. FMT has shown promise in treating conditions like Clostridium difficile infections, which are resistant to antibiotics. The process is still being studied, but early results are encouraging.
Future Research Directions
The field of microbiome research is rapidly evolving. Scientists are exploring new ways to manipulate the microbiome to treat various diseases. Future research may focus on personalized medicine, where treatments are tailored to an individual's unique microbiome. This could lead to more effective therapies for conditions like obesity, diabetes, and even mental health disorders.
The potential of the microbiome in medicine is vast, offering new hope for treating a range of diseases. As research progresses, we may see more innovative therapies that harness the power of these tiny organisms.
Challenges and Future Directions in Microbiome Research
Technological Advances
The study of the microbiome has greatly benefited from new technologies like high-throughput sequencing. These tools allow scientists to analyze the complex communities of microbes in our bodies. However, there is still a lot to learn about how these microbes interact with each other and with their human hosts. Future research will need to focus on improving these technologies to get even more detailed information.
Ethical Considerations
As we learn more about the microbiome, ethical questions arise. For example, who owns the data collected from someone's microbiome? How should this information be used? Researchers must consider these questions to ensure that microbiome research is conducted responsibly.
Personalized Medicine
One exciting area of future research is personalized medicine. By understanding an individual's unique microbiome, doctors could tailor treatments specifically for them. This could lead to more effective therapies with fewer side effects. However, more research is needed to make this a reality.
The microbiome is a living, dynamic environment that changes with diet, medication, and other factors. Scientists are just beginning to understand its broad role in health and disease.
Some current research topics include:
- How the microbiome and its metabolites affect human health and disease.
- Factors that influence the balance of the microbiome.
- Development of probiotics as functional foods and addressing regulatory issues.
- Creating diagnostic biomarkers from the microbiome to identify diseases early.
- Altering the microbiome through methods like fecal transplantation.
Conclusion
The study of the microbiome is still in its early stages, but what we know so far is fascinating. These tiny organisms living inside and on us play a big role in our overall health. They help us digest food, protect us from harmful bacteria, and even influence our mood and mental health. Keeping a healthy balance of these microbes can lower the risk of many diseases, including obesity, heart disease, diabetes, and cancer. As research continues, we will learn even more about how to use this knowledge to improve our health and well-being. The future of microbiome research holds great promise for new treatments and a better understanding of how our bodies work.
Frequently Asked Questions
What is the microbiome?
The microbiome is a collection of tiny organisms like bacteria, viruses, and fungi that live in and on our bodies. They are found on our skin, in our mouths, and throughout our digestive system.
Why is the gut microbiome important?
The gut microbiome helps us digest food, supports our immune system, and even affects our mood and mental health. A healthy gut microbiome can lower the risk of diseases like obesity, heart disease, and diabetes.
How does the microbiome affect our health?
The microbiome plays a big role in our overall health. It helps with digestion, protects against harmful germs, and can even influence our mental well-being. Researchers are still studying all the ways it impacts us.
Can diet change the microbiome?
Yes, what you eat can change your microbiome. Eating a variety of fruits, vegetables, and fermented foods can help keep your microbiome healthy. On the other hand, a diet high in sugar and processed foods can harm it.
What are probiotics and prebiotics?
Probiotics are good bacteria found in foods like yogurt that can help your microbiome. Prebiotics are foods that feed these good bacteria, like fiber-rich fruits and vegetables.
What is fecal microbiota transplantation?
Fecal microbiota transplantation is a medical procedure where healthy bacteria from a donor's stool are transferred to a patient's gut. This can help restore a healthy microbiome and treat certain diseases.